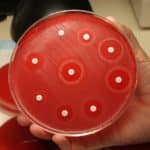

Home Search
biology - search results
If you're not happy with the results, please do another search
Massive Recruitment Drive @ Biocon with 53 Openings in Quality Control ( Formulations) Domain
Biocon is an integrated biotechnology enterprise focused on the development of biopharmaceuticals. With successful initiatives in drug discovery and development, bioprocessing, manufacturing and global...
Research Fellow Vacancy For Biotech & Life Science Candidates @ Manipal University
Manipal University is synonymous with excellence in higher education. Over 28,000 students from 57 different nations live, learn and play in the sprawling University town, nestled on a...
Periyar University Announces Opening For JRF In DST Project
Periyar University imparts higher education at three levels, i.e., through its Departments of Study and Research, Periyar Institute of Distance Education (PRIDE) and the...
Computing Genetic Ancestors Has Become Super Accurate
Remnants of extinct monkeys are hiding inside you, along with those of lizards, jellyfish and other animals. Your DNA is built upon gene fragments...
Two-Faced – Do Genes Decide Responses To Schizophrenic Drug?
A drug prescribed to many patients with schizophrenia or bipolar disorder may decrease negative symptoms for people with a certain variant of the COMT...
Multiple Openings For UNSRF@ Madurai Kamaraj University
Madurai Kamaraj University, is on its relentless journey for the past 48 years surmounting hurdles of indigenous and exotic nature on its way and...
Apply For Junior Research Fellow Opening @ ARI, Pune || Earn Rs 25,000+
Agharkar Research Institute (ARI) is an autonomous institute of the Department of Science and Technology (DST), Government of India. It was established in 1946...
Attend Walk-in interview for two posts of SRF @ TANUVAS, Chennai | Earn up...
The seed for the establishment and growth of TANUVAS was sown as early as 1876, when the Madras Veterinary College was started as an...
Post of Scientist B Vacant @ Centre for Research in Medical Entomology, Madurai
Situated at Madurai in Tamil Nadu, the Centre for Research in Medical Entomology (CRME), conducts research on various medico-entomological disciplines especially ecology, physiology, molecular...
Work as an Executive in a Micro lab @ Mondelez India Foods Ltd
Work as an Executive in a Micro lab @ Mondelez India Foods Ltd
Mondelēz India Foods Ltd is a leading global confectionery & snacks company....
Researchers find Novel Evolutionary Pathways of Drug Resistance by Spreading E.coli on MEGA Petri...
Researchers find Novel Evolutionary Pathways of Drug Resistance by Spreading E.coli on MEGA Petri Dish
Lights! Camera! Drug Resistance!
We believe what we see ... so...
How the Brain Builds 3D Panoramic Memory
How the Brain Builds 3D Panoramic Memory
When asked to visualize your childhood home, you can probably picture not only the house you lived in,...
Work as Technical Assistant @ Central Drug Research Institute | Earn Up to Rs....
Work as Technical Assistant @ Central Drug Research Institute | Earn Up to Rs. 36,675 p.m.
Opportunity for technically qualified persons to join as Technical...
Reshaping Ecosystems Through Gene Drive: Environmentalists Show Concern
Reshaping Ecosystems Through Gene Drive: Environmentalists Show Concern
Scientific techniques that can wipe out invasive species or alter mosquitoes’ ability to carry disease are pushing...
Why can’t we stop hereditary diseases from passing to next generation | Here’s the...
Why can't we stop hereditary diseases from passing to next generation | Here's the answer
Some diseases are hereditary that are passed on to next...